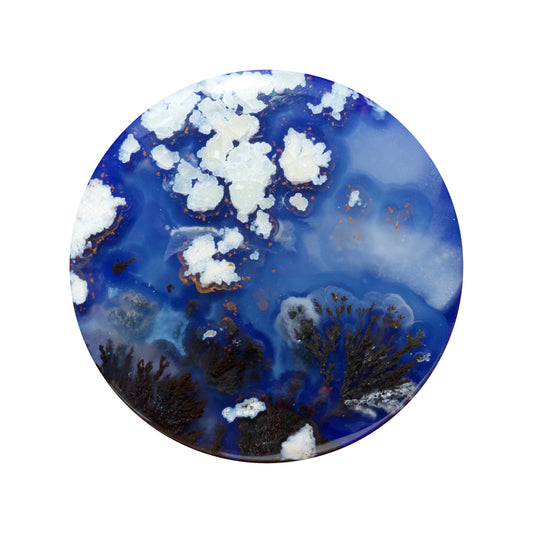

Blog

Lost Wax Casting + Organics
I thought it was time to share! I've been fielding a lot of questions about casting metal, and over the last few months I created a little list of quick...
Lost Wax Casting + Organics
I thought it was time to share! I've been fielding a lot of questions about casting metal, and over the last few months I created a little list of quick...

Scenic Other Worlds
I've been thinking about my solo exhibition at the Mohr Gallery in Mountain View, California. The show featured jewelry and photographs of rocks. It was a lot of fun! Check out...
Scenic Other Worlds
I've been thinking about my solo exhibition at the Mohr Gallery in Mountain View, California. The show featured jewelry and photographs of rocks. It was a lot of fun! Check out...

Cuttlefish Bone Casting Part II
I recently purchased an electric melting furnace for the ability to cast metal in the absence of a torch. The immediacy and direct nature of cuttlefish bone casting makes it a natural...
Cuttlefish Bone Casting Part II
I recently purchased an electric melting furnace for the ability to cast metal in the absence of a torch. The immediacy and direct nature of cuttlefish bone casting makes it a natural...
Doublets
There are truly little worlds in that quartz clarity. A doublet is the lapidary term for a gem assembly that consists of two stones that have been joined together with...
Doublets
There are truly little worlds in that quartz clarity. A doublet is the lapidary term for a gem assembly that consists of two stones that have been joined together with...

Cuttlefish Bone Casting
I have always been drawn to this ancient method of direct casting using gravity and the buoyant structure of the beloved cephalopod.
Cuttlefish Bone Casting
I have always been drawn to this ancient method of direct casting using gravity and the buoyant structure of the beloved cephalopod.

Polishing + Patinas
Discoloration on the surface of many metal alloys is common and called by a variety of names: patina, oxidation, tarnish.
Polishing + Patinas
Discoloration on the surface of many metal alloys is common and called by a variety of names: patina, oxidation, tarnish.